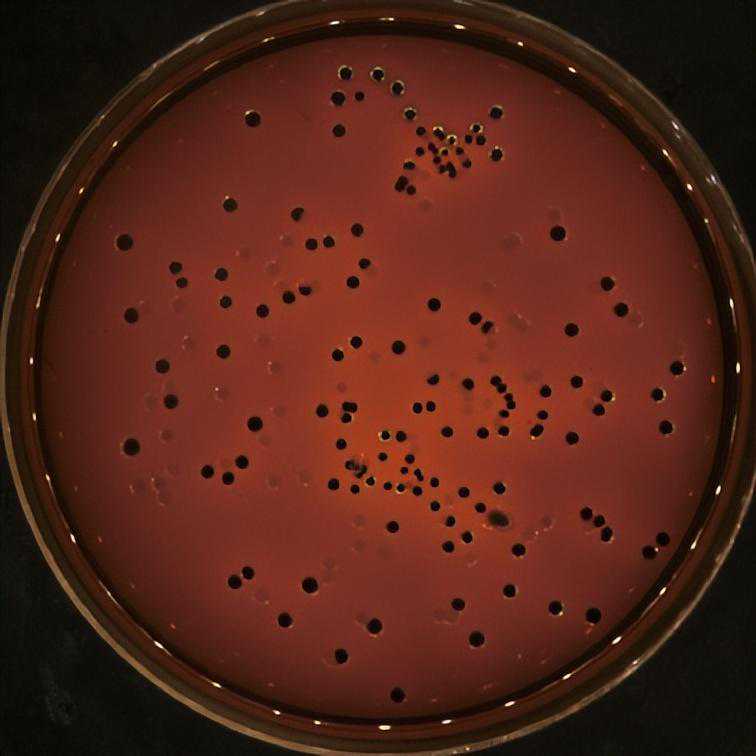
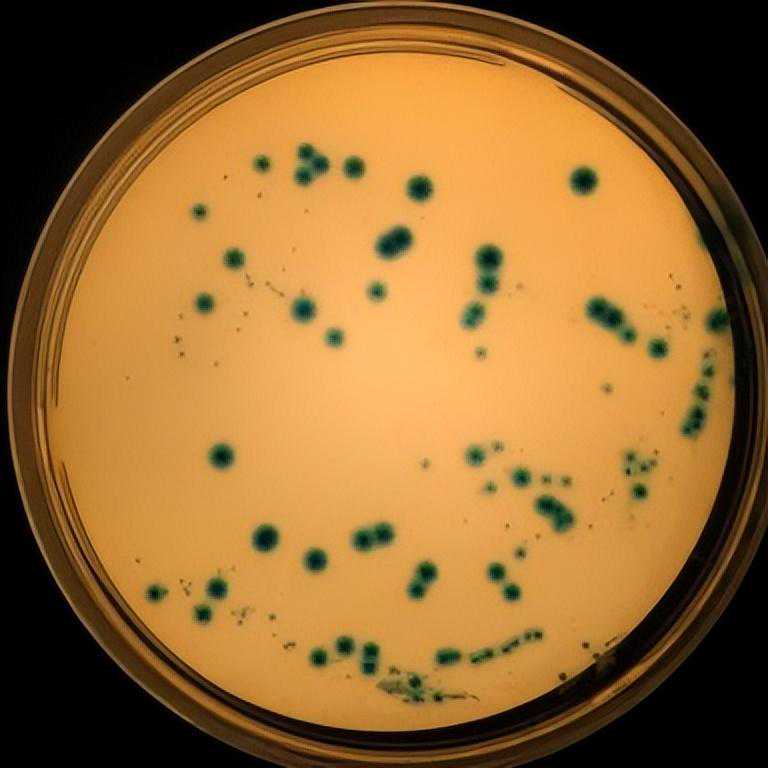
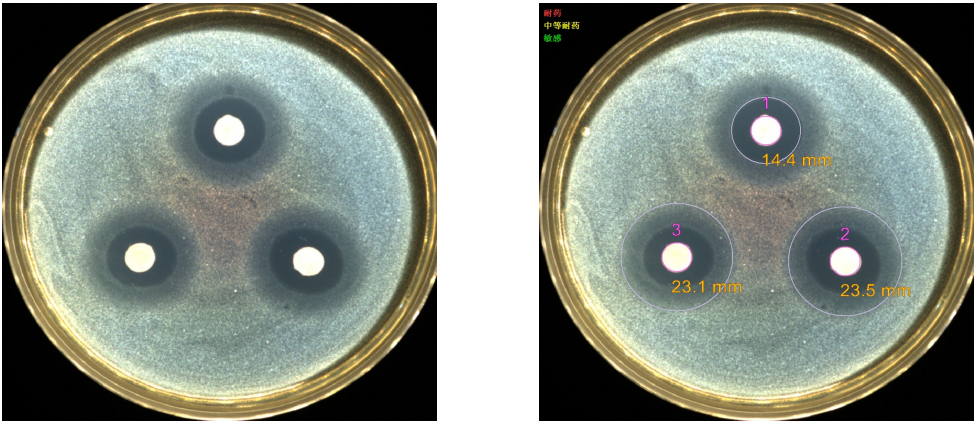
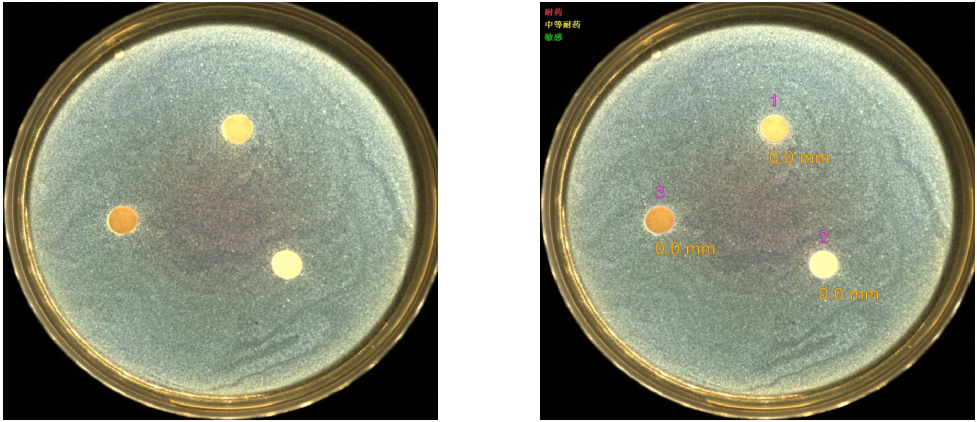

抵抗由微生物感染引发的各种疾病是医学中的重要研究方向,有没有正奋斗在抗菌科研前线的小伙伴呢?我们也来为微生物实验添砖加瓦,为抗菌科研用户提供切实帮助。
细菌真菌千千万,培养条件各不同。要了解微生物首先要建立良好的培养体系,决定细菌培养的两大要素主要是氧气和培养基,针对微需氧和厌氧菌,我们实验室配备了ANOXOMATMARKII厌氧微需氧培养系统(荷兰),可快速提供厌氧和微需氧环境,解决各类微生物需氧不同问题。
培养基的选用也是决定细菌生长状态的关键因素,实验室常备数十种微生物培养基及各种添加剂,具备丰富的培养条件调试经验,成功帮助众多科研小伙伴脱离培养困境。
我们培养过的菌株包括铜绿假单胞菌、肺炎克雷伯杆菌、金黄色葡萄球菌、幽门螺旋杆菌、具核梭杆菌、牙龈卟啉单胞菌、军团菌、阿萨希毛孢子菌、烟曲霉、产气荚膜梭菌、单形拟杆菌、肺炎链球菌等等,遇到微生物分离培养问题的小伙伴,都可以来交流经验哦~

不同菌株的选择性培养

ANOXOMATMARKII厌氧微需氧培养系统
针对微生物的研究,培养仅仅是迈出了第一步,接下来我们为大家介绍一类比较常见的微生物研究方向耐药研究的常见思路:
2.进行细菌或者真菌耐药性筛选:比如青霉素、左氧氟沙星、庆大霉素、头孢曲松等;
3.根据耐药性对比发现对照菌株和耐药菌株对某种抗生素的抗性差别很大,例如对四环素差别很大,那么可以测对照菌株和耐药菌株的转录组测序,查找耐药性和哪些基因相关;同时也可以参考文献找出抗四环素的基因,进行表达量检测;
4.确定在对照菌株和耐药株之间是A、B、C等基因表达量有差异,在耐药株或者对照菌株中进行A基因敲除或者沉默表达;
5.针对对照菌株、敲除株、耐药株、耐药敲除株进行相关机制检测
(1)致病性检测:动物体内注射病菌进行致病性判断;
(2)体外实验:将上述菌株感染A549细胞,检测不同时间点乳酸脱氢酶的活性;
(3)粘液表型鉴定:拉丝实验
(4)QPCR和WB:检测毒力相关基因表达量变化;
(5)耐药分子机制研究:将敲除基因的下游信号通路基因进行QPCR和WB检测;
(6)结晶紫染色比较不同菌株间的生物膜形成能力;
(7)XTT检测不同菌株之间的代谢活性;
(8)活死染色检测不同菌株之间在药物处理下(或其他处理)的细胞活死比例;
(9)扫描电镜观察细菌的结构改变;
(10)对菌株进行GFP荧光标记或者LUC标记,注射体内或者细胞共培,观察细菌变化动态或者筛选作用;
下面简单介绍一下这些实验的步骤和结果形式,给各位科研小伙伴们作为参考,如果有疑问也可以一起交流分享~、
一、首先比较不同临床分离株(或者不同土壤、水质等环境中的分离株)的耐药特性,常见方法有药敏片法和MIC测定,根据耐药特性不同分为耐药株和敏感株,比较两类菌株中目标基因的表达量差异,确定目标基因与耐药性是否关联。
1.MIC实验步骤——幽门螺旋杆菌
(1)BHIS固体培养基配制:称取BHI培养基干粉52g,琼脂1.5g,加热搅拌溶解于900ml蒸馏水中,121℃高压灭菌15min,临用前加热溶化琼脂,冷至50℃左右,按照10%比例添加脱纤维羊血,摇匀后倾入无菌平皿冷却备用。
(2)BHI血清液体培养基配制:称取BHI培养基干粉52g,加热搅拌溶解于900ml蒸馏水中,121℃高压灭菌15min,冷至后,加入胎牛血清(终浓度10%),维生素K1(终浓度0.001mg/ml)和氯化血红素(终浓度0.002mg/ml)。
(3)将幽门螺旋杆菌种于上步平板上划线,37℃微需氧(6%O2,7%CO2,7%H2,80%N2)培养3d左右至可见明显菌斑。
(4)挑取适量成熟菌落,至5ml液体培养基中37℃微需氧培养16~18h,至OD600约0.6,生理盐水调整至0.6。按照0.1%的比例接入到2×BHI血清培养基溶液中,取1ml该菌液加入初始孔中,剩余菌液加入等体积水后,取1ml加入到其余孔中。
(5)初始孔加药:取1ml测试药物母液加入到初始孔菌液中。然后从初始孔中吸取1ml液体加入到第二孔菌液中,混合后再从第二孔中吸取1ml液体加入到第3孔中,依次至第11孔,第11孔弃掉1ml液体。阴性对照组以水补充,37℃微需氧震荡培养7d。
(6)取出深孔板,吸取200ul至96孔酶标板检测OD600值,之后超净台静置30min,肉眼观察菌体沉淀情况。
(7)结果判读:MIC(minimuminhibitoryconcentration)最低抑菌浓度,在微生物鉴定的稀释法中以在试管内或小孔内完全抑制细菌生长的最低药物浓度为最低抑菌浓度。即OD值接近药物阴性对照组的最低药物浓度。

2.纸片扩散法抑菌圈实验
(1)滤纸片准备:用打孔器将滤纸片制备成直径为0.6cm的圆片,进行121℃20min高温灭菌
(2)将测试菌种于LB平板上划线37℃培养过夜至可见明显菌斑。
(3)挑取适量成熟菌落,至5mlLB液体培养基中37℃培养6-8h,至OD600约0.6,生理盐水调整至0.6。
(4)LB琼脂培养基高压灭菌冷却至40~50℃,按照0.1%比例接入测试菌液(即100ml培养基中加入OD600值为0.6的菌液100ul),混匀后倒入培养皿中冷却凝固
(5)待含菌培养基凝固后,放入3个滤纸片。
(6)滤纸片加药体积:
卡那霉素5mg/ml:10ul
药物900:10ul
(7)37℃培养18h,拍照记录并分析细菌抑菌圈大小。

3.敲除菌株构建
不同的细菌或真菌,其进行基因组改造的遗传操作体系各不相同,针对不同的细菌需要使用不同的质粒骨架进行敲除株和回补株构建。目前我们基因组改造的菌种有粪肠球菌、变形链球菌、铜绿假单胞菌、金黄色葡萄球菌、白念珠菌、幽门螺旋杆菌、乳酸菌、芽孢杆菌、曲霉、马尔尼菲篮状菌等。

敲除株构建大致路线
4.其他染色实验或者数据展示
不同基因功能不同,模型不同,因此后续检测实验种类繁多,暂时展示部分以供各位小伙伴参考,具体适合各位课题中的实验方法还是需要参考文献进行实验为好。

结晶紫染色比较不同菌株间的生物膜形成能力

活死染色比较不同菌株在相同药物处理下的活死比例差异

扫描电镜比较菌体形态及生物膜形成情况差异

GFP标记菌株的培养及荧光强度观察

LUC标记菌株的培养及活体成像观察




















